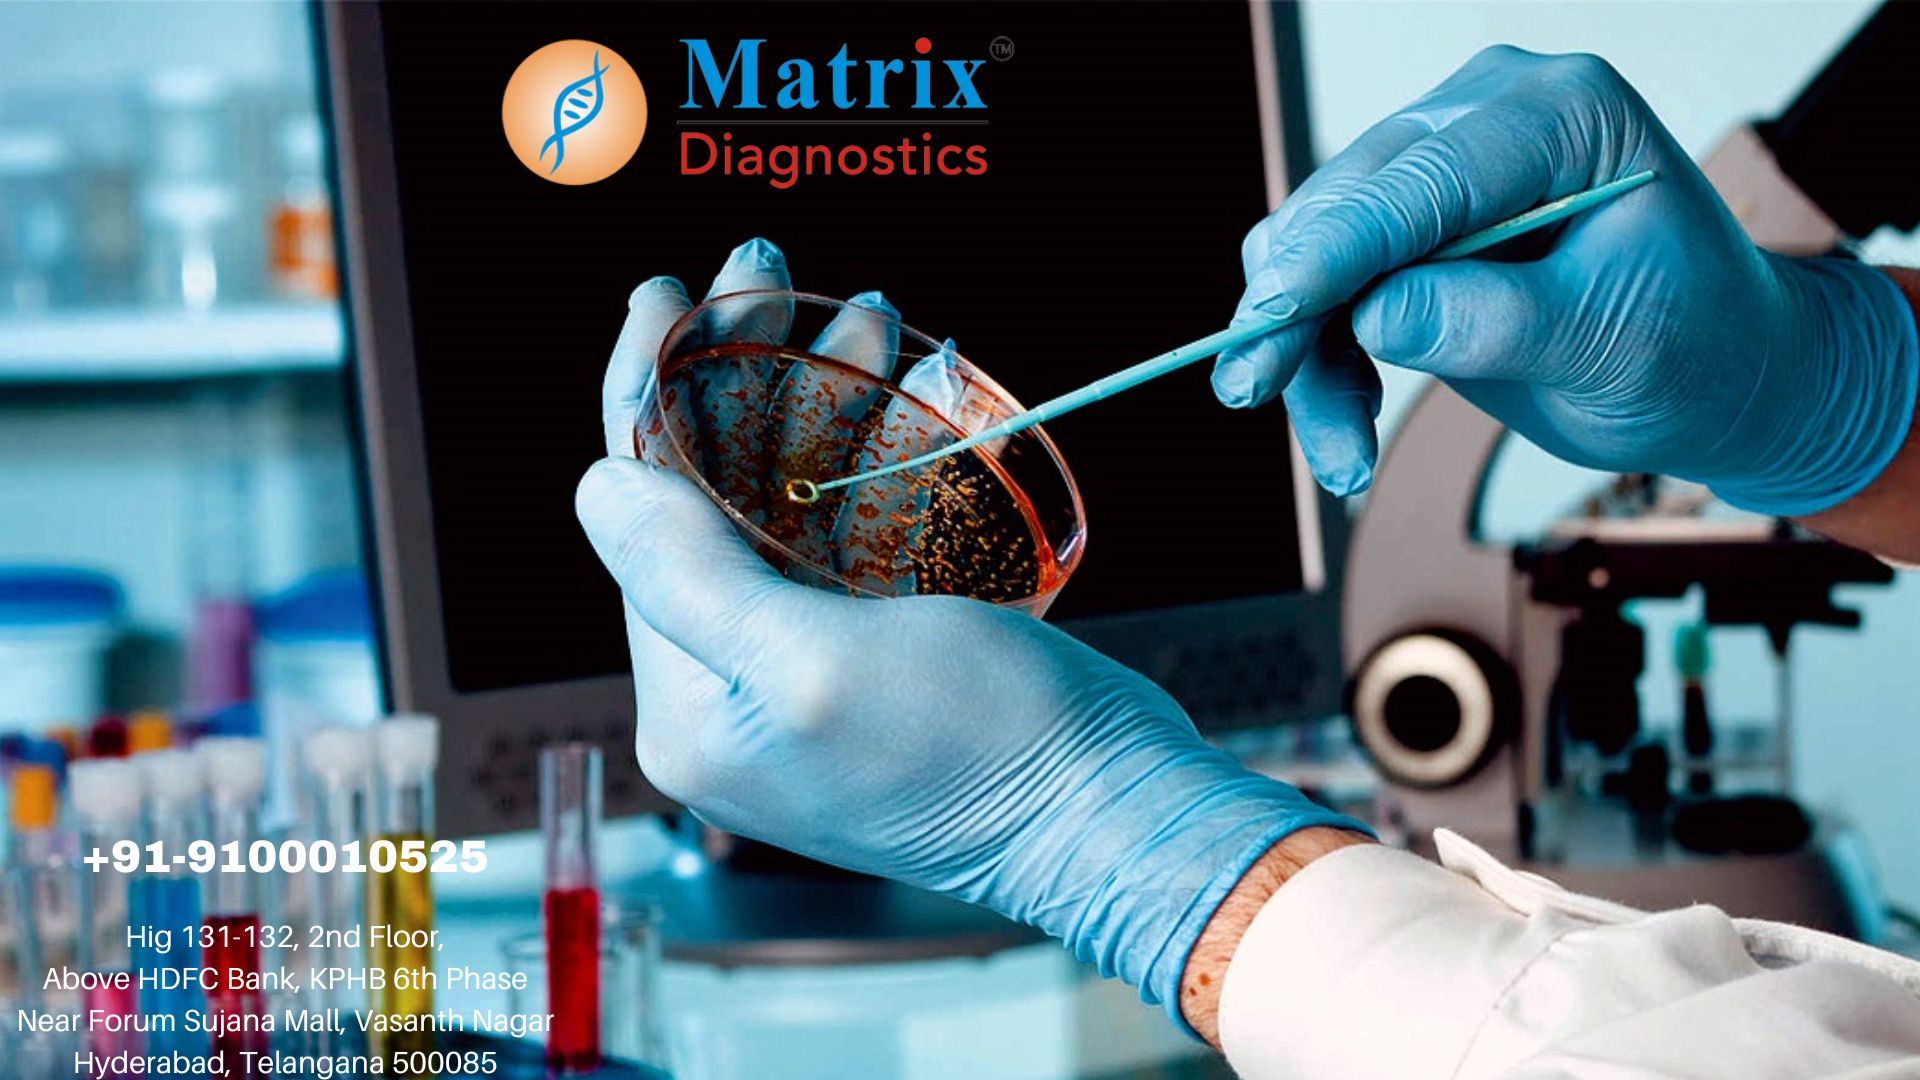
img

Lab tests and diagnostic procedures are tests used to check if a person’s health is normal. GHI Diagnostics Specialty labs can test a sample of your blood, urine or body tissue to see if anything is wrong. A diagnostic test, like blood pressure testing, can show if you have low or high blood pressure.
GHI Diagnostics Specialty Labs have the best of facilities for providing Accurate Medical Diagnostics to patients. Along with our team of Expert Physicians and Doctors we are always striving towards giving the best of our services
Award Winning
Professional Staff
24/7 Opened
Fair Prices
GHI Diagnostics Specialty Labs - Good Health India Diagnostics Specialty Labs is started by a team of Senior Doctors and Healthcare professionals who have extensive experience in patient care for more than 20 years. We are compassionate in providing high quality, affordable diagnostics, screening and therapeutic services.
Related Searches Are: best diagnostics center in hyderabad, diagnostic services in Hyderabad, diagnostic lab near me, best health packages in hyderabad, best diagnostics in hyderabad, medical diagnostic center in hyderabad, medical diagnostic laboratory in banjara hills, basic health packages in hyderabad, medical health packages in hyderabad, specialty labs in hyderabad, speciality labs in banjara hills, ghi speciality labs, multi specialty labs in hyderabad, multi specialty labs in banjara hills, ghi multi speciality labs, Best centre for Allergy testing in Hyderabad, dvt/coagulation/thrombophilia tests in hyderabad.
For More Info: https://www.ghidiagnostics.com
or
Call Us: +91 80746 42987